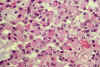

Vol. 35, n.º 4, 2002
REVISTA
ESPAÑOLA DE
Vol. 35, n.º 4, 2002 |
Julio Escalona Zapata, Gonzalo Miranda Nieves, Manuel Gutiérrez Molina, Armando M. Martínez
Servicio de Anatomía Patológica. Hospital General Universitario Gregorio Marañón. Laboratorio de Cultivo de Tejidos.
RESUMEN
La existencia de oligodendrocitos y astrocitos en los tumores mixtos se ha querido explicar por varias teorías: 1. Un origen a partir de dos líneas celulares distintas; 2. Inducción neoplásica de un tumor sobre las células vecinas; 3. Existencia de una única célula originaria procedente de la línea celular A2B5, capaz de dar lugar a oligodendrocitos y astrocitos.
Hemos estudiado una serie de 124 oligodendrogliomas con los siguientes métodos: 47 casos con impregnación argéntica de Rio-Hortega; 77 casos con inmunotinción para GFAP; 11 casos con cultivo de tejidos a corto plazo y 8 líneas permanentes en monocapa.
Este estudio demuestra que: 1. Una parte de los astrocitos son células atrapadas dependientes de la gliosis peritumoral; 2. Existen numerosos oligodendrocitos capaces de expresar GFAP y con argentofilia pertenecientes a la población tumoral; 3. Las células explantadas en los dos tipos de cultivo han expresado GFAP.
En base a ello consideramos que, bajo ciertas condiciones, la oligodendroglía es capaz de exhibir rasgos astrocíticos y que, en consecuencia, los tumores mixtos son oligodendrogliomas con metaplasia astrocítica.
Palabras clave: Oligodendroglioma, Oligodendrocitos eosinófilos (minigemistocitos), Cultivo de tejidos, Metaplasia astrocítica.
SUMMARY
The existence of tumoral oligodendrocytes and astrocytes in mixed gliomas has been explained in several ways: 1. Originating from two distinct cell lines; 2. Resulting from neo-plastic induction of a previous tumor on the peripheral cells or; 3. From a single original cell of A2B5 lineage, capable of developing into oligodendrocytes and astrocytes.
124 oligodendrogliomas were revised: 47 cases underwent Rio-Hortega silver staining; 77 cases were stained for GFAP; 11 cases by short term tissue cultures; 8 cases by per-manent cell lines established in monolayer cultures.
Our findings are as follows: 1. A part of the astrocytes were trapped cells dependent on the peritumoral gliosis. 2. Several oligodendroglial cells in the tumoral population ex-pressed GFAP and showed argentofilia. 3. Both types of cultures developed expression of GFAP in vitro.
In conclusion, we consider that oligodendroglia can, under certain conditions, develop some astrocytic features and that the so-called «mixed tumors» are the consequence of an astrocytic metaplasia in oligodendroglioma.
Key words: Oligodendroglioma, Eosinophilic oligodendrocytes (minigemistocytes), Tissue culture, Astrocytic metaplasia.
INTRODUCCIÓN
La descripción de astrocitos en el interior de oligodendrogliomas y viceversa, de oligodendroglía en el interior de astrocitomas expresa un cierto grado de confusión en cuanto a la naturaleza de estas neoplasias que arranca con los trabajos de Cooper (1935) y De Buscher y Scherer (1942) pero no termina de asentarse hasta la aportación de Hart y cols (1974) cuando describieron, bajo el término de tumores mixtos, neoplasias cerebrales en las que participaban oligodendrocitos y astrocitos. Estos tumores respondían a dos patrones, uno formado por neoplasias con distribución desordenada de astrocitos y oligodendrocitos, mezclados en la misma masa tumoral y otro, en el que coexistían áreas de oligodendroglioma y de astrocitoma bien diferenciado, separadas entre sí.
Por otra parte, la existencia de células con rasgos astrocitarios en el seno de oligodendrogliomas había sido ya descrita, siendo su máxima expresión el llamado minigemistocito, célula de morfología general oligodendróglica, pero dotada de un citoplasma opaco y eosinófilo (Escalona Zapata 1981, Meneses y Kepes 1982, Herpers y Budka 1984) (figs. 1 y 2). Igualmente, se ha descrito la existencia de oligodendrocitos en el interior de astrocitomas de bajo grado (Russell y Rubinstein 1989).
Fig. 1. Oligodendroglioma
eosinófilo. Células densamente diespuestas, con núcleo redondo lateralizado y
abundante citoplasma eosinófilo y opaco (minigemistocitos ) (H-E 200x).

Fig. 2. Oligodendroglioma
eosinófilo. Las células muestran características morfológicas
oligodendróglicas, pero poseen gliofilamentos en su citoplasma (Rio-Hortega
400x).
Por último, no debe olvidarse la existencia de oligodendroglía no tumoral, incluida en el interior de astrocitomas así como de numerosos astrocitos reactivos como parte del intersticio de cualquier glioma suficientemente infiltrante (Escalona Zapata 1994).
La existencia de estas neoplasias mixtas ha dado lugar a distintos puntos de vista en relación con su histogénesis, por lo que hemos llevado a cabo un estudio de un amplio grupo de oligodendrogliomas, con la intención de aclarar las relaciones entre ambos tipos celulares, oligodendroglía y astrocitos, cuando forman parte de un crecimiento tumoral.
MATERIAL Y MÉTODOS
El presente trabajo se basa en el estudio del siguiente material:
124 oligodendrogliomas procedentes de los Servicios de Anatomía Patológica del Hospital General Universitario Gregorio Marañón (Madrid), Hospital Universitario La Paz (Madrid) y Hospital Clínico de San Carlos (Madrid).
Estos casos se han estudiado por medio de las técnicas más selectivas para la demostración de los astrocitos:
A. Doble impregnación argéntica en caliente (Río-Hortega 1943) e impregnación rápida en frío (Polak 1966) que se aplicó a 47 casos.
B. Tinción inmunohistoquímica por medio de suero anti GFAP que se aplicó a 77 casos.
C. Cultivo de tejidos a corto plazo según la técnica propuesta por Kersting (1961) modificada por Escalona Zapata y Diez Nau (1983) que se aplicó a 11 casos.
D. Establecimiento de líneas celulares permanentes según la pauta propuesta por Miranda Nieves (1989) que se aplicó a 7 casos.
RESULTADOS
En base a los resultados obtenidos, pueden establecerse los siguientes grupos:
Grupo I. En 58 casos los tumores fueron homogéneos, con células de mediano tamaño, núcleo redondo normocrómico o discretamente hipercrómico y citoplasma claro, con neta membrana. La asociación celular fue sólida, con una típica imagen en panel de abejas, con presencia sólo ocasional de pequeños quistes. La vascularización fue de capilares, frecuentemente dicotomizados en ángulo recto. Sólo se presentaron calcificaciones en el 30 de los casos. Se trata por lo tanto de oligodendrogliomas convencionales.
En el interior de estos tumores no se encontraron células astrocíticas, demostrables con ninguna de las dos técnicas empleadas, y sólo pudieron objetivarse astrocitos en la periferia de las lesiones, en forma de gliosis reactiva. Estas células se detenían en el borde de crecimiento del tumor, mostrando en general discretos signos de progresividad (figs. 3a y 3b).

Fig. 3a. Astrocitos reactivos en
las áreas de glicosis peritumoral. Obsérvese la infiltración interfascicular
de pequeños grupos de células tumorales (GFAP 200x).

Fig. 3b. Intensa gliosis pertumoral
con células de citoplasma abundante y argentófilo y numerosas expansiones
finas (Rio-Hortega 400x).
Grupo II. En 19 casos los tumores presentaron astrocitos demostrables con ambos métodos en número variable, tanto alrededor del tumor como en el grupo I, como en el interior del tejido tumoral. Estas células fueron constantemente mayores que los oligodendrocitos tumorales y mantuvieron las mismas características de la gliosis periférica con un citoplasma abundante e hinchado y numerosas expansiones de disposición estrellada. En la mayor parte de los casos, los astrocitos intratumorales se densificaron cerca de la gliosis peritumoral y alrededor de los vasos de la neoplasia a cuyo nivel tomaban contacto con la adventicia. De este modo se cumplen los criterios de los astrocitos atrapados durante el crecimiento infiltrante de oligodendrogliomas convencionales (figs. 4a y 4b).

Fig. 4a. Numerosos astrocitos
adultos atrapados entre las células tumorales (GFAP 200x).

Fig. 4b. Astrocitos adultos
formando parte del intersticio no tumoral en un oligodendroglioma (Rio-Hortega
400x).
Grupo III. En 22 casos se obtuvo impregnación argéntica citoplásmica y expresión de GFAP en células con patrón oligodendróglico. Estas células fueron siempre de menor tamaño que los astrocitos de los dos grupos anteriores y exhibieron un núcleo central, redondo y un citoplasma algo más opaco y eosinófilo que las típicas células claras de los oligodendrocitos tumorales. De ellas, unas presentaron un citoplasma redondo a modo de un halo perinuclear carente de expansiones (figs. 5a y 5b), en tanto que otras mostraban prolongaciones únicas o muy escasas, a veces flexuosas (fig. 6a y 6b). Se mostraron más independientes de los vasos y nunca hubo relación de continuidad con la gliosis peritumoral.

Fig. 5a. Numerosas células de
morfología oligodendróglica muestran un citoplasma apolar, con intensa
expresión de GFAP (GFAP 200x).

Fig. 5b. Con impregnaciones
argénticas, los resultados son semejantes, con células de hábito
oligodendróglico y citoplasma intensamente argentófilo, casi siempre apolar
(Rio-Hortega 200x).

Fig. 6a. En este caso predominan
las células monopolares, con citoplasma capaz de expresar GFAP (GFAP 200x).

Fig. 6b. Al igual que en la imagen
con GFAP, las células se muestran monopolares e intensamente argentófilas
(Rio-Hortega 400x).
Grupo IV. En 25 casos, con ambas técnicas se demostraron células oligodendróglicas con características tintoriales y morfológicas propias de los astrocitos. Estas células yacían sin orden alguno, salpicadas entre los oligodendrocitos tumorales o formando pequeñas agrupaciones en el interior de la neoplasia. Su tamaño era algo mayor, su núcleo más oval y su citoplasma abundante, con numerosas expansiones, de las que algunas terminaban implantándose en los capilares (figs. 7a y 7b).

Fig. 7a. Células más
evolucionadas, ya con cierto hábito astrocítico, como la del centro de la
imagen, emiten ya varias expansiones con expresión de GFAP (GFAP 200x).

Fig. 7b. También en las
impregnaciones argénticas aparecen algunas células argentófilas multipolares
(Rio-Hortega 200x).
Estos cuatro grupos distan de ser homogéneos y, en la mayor parte de los casos coexistían células atrapadas y células de los grupos III y IV, distinguiéndose unos grupos de otros por los porcentajes relativos encontrados de cada tipo celular.
Grupo V. 11 oligodendrogliomas, 10 de patrón clásico y 1 caso eosinófilo fueron estudiados por medio del cultivo de tejidos a corto plazo según las pautas propuestas por Kersting (1961) y modificadas por Escalona-Zapata y Diez Nau (1983). En todos los casos, el crecimiento fue el propio de estas neoplasias, con desarrollo inicial reticular, seguido de una fase de emigración de células de citoplasma redondo y expansiones finas, escasas y largas, formando ocasionalmente agrupaciones de entre 8 y 20 células. Entre estos grupos había espacios areolares (Cases Huerta 1989; Escalona-Zapata 1996) (fig. 8).

Fig. 8a. Grupo de células muy
transformadas, con numerosas expansiones y con hábito claramente astrocítico.
Obsérvese el menor tamaño en relación con los astrocitos de las imágenes de
las figuras 3 y 4 (GFAP 200x).

Fig. 8b. De nuevo las
impregnaciones argénticas reproducen la imagen del método inmunohistoquímico,
con elementos multipolares de pequeño tamaño (Rio-Hortega 200x).
El caso eosinófilo mostró el mismo patrón de desarrollo, manteniéndose la morfología citoplásmica panzuda, opaca y eosinófila (Escalona-Zapata 1981) (fig. 9).

Fig. 9. Oligodendroglioma
convencional. Cultivo de tejidos a corto plazo al 12 día de explantación.
Emigración de pequeñas células de núcleo redondo y escasas expansiones finas
y largas que se pierden en los tractos más densos que delimitan las areolas
(H-E 100x).
El fenómeno más interesante fue la expresión de GFAP que tuvo lugar en todos los casos, incluida la variante eosinófila, en un periodo inicial a los 9 días, en los casos más precoces, y que se mantuvo hasta el final de la vida del cultivo (fig. 10).

Fig. 10. Oligodendroglioma
eosinófilo. Cultivo de tejidos a corto plazo a los 18 días de explantación.
Las células son algo mayores debido a la persistencia de un abundante
citoplasma eosinófilo, pero mantienen un núcleo redondo y unas expansiones
escasas y finas (minigemistocitos) (H-E 200x).
Grupo VI. 8 oligodendrogliomas fueron estudiados por medio del cultivo de tejidos estableciéndose otras tantas líneas estables que persistieron por periodos superiores a 1 año. Dado su carácter de monocapa, los resultados morfológicos variaron levemente en relación con los obtenidos en los cultivos a corto plazo, pero se cumplieron los criterios habitualmente establecidos. Al cabo de periodos variables, siete de las 8 líneas celulares fueron capaces de expresar GFAP en el citoplasma de sus células (fig. 11).

Fig. 11. Oligodendroglioma
convencional. Cultivo de tejidos a corto plazo a los 18 días de explantación.
Todas las células expresan GFAP (cortesía del Prof. J. J. Kepes, Kansas City)
(GFAP 200x).

Fig. 12. Oligodendroglioma
convencional. Cultivo en monocapa en una línea permanente. También las
células de la línea, aun manteniendo su morfología oligodendróglica, son
capaces de expresar GFAP (GFAP 400x).
DISCUSIÓN
La concepción del oligodendroglioma como un tumor monomorfo, resultado de una imagen celular en «huevo frito» con íntima asociación en el patrón llamado en «panal de abejas» es sólo cierta en algo menos del 90 % de los casos. El resto está formado por las formas anómalas o inusuales (Escalona Zapata 1981) que presentan una marcada heterogeneidad (Escalona Zapata 1996). Esta heterogeneidad citológica, no se limita a los tumores sino que aparece en la propia oligodendroglía normal y en ella se incluyen no sólo la forma clásica de oligodendroglía, de soma redondo y escasas expansiones cortas (tipo I), sino los tipos II, III y IV, de mucha mayor complejidad (Río-Hortega 1928). En el mismo sentido, los propios oligodendrogliomas muestran células que se apartan del patrón habitual tanto en su totalidad, como en campos aislados. Independientemente de los tumores polimorfos, de células fusiformes o pseudoastrocitomatosos (Escalona-Zapata 1996), aparecen también tumores con elementos de núcleo lateralizado, citoplasma panzudo, opaco y eosinófilo que han sido llamados minigemistocitos (Escalona Zapata 1981; Meneses y Kepes 1982; Herpers y Budka 1984). Estas células poseen gliofilamentos pero mantienen el patrón in vitro propio de las formas clásicas de oligodendrogliomas.
En sentido contrario, Russell y Rubinstein (1989) han demostrado la existencia de oligodendroglía en astrocitomas hemisféricos.
Un factor más, que complica la fina citología de los oligodendrogliomas, es la existencia de abundantes astrocitos adultos, atrapados en el interior de numerosos oligodendrogliomas y que pueden inducir a errores al ser considerados como células tumorales diferenciadas en este sentido (Escalona Zapata 1994).
A pesar de ello, la existencia de tumores mixtos está fuera de toda duda. De ellos, los casos en que coexisten áreas separadas de oligodendroglioma y de astrocitoma, no plantean problemas, en cuanto a su carácter de neoplasia mixta, pero no es así cuando las células de hábito oligodendróglico y astrocítico yacen mezcladas (Burger y Scheithauer 1994).
El problema reside en la definición de los mecanismos histogenéticos que llevan a su desarrollo. En un principio, Hart y cols (1974) defendieron la existencia de dos líneas celulares diferentes, que bajo la acción de los mecanismos oncogénicos, determinarían la formación de un tumor con dos tipos de células. Este punto de vista está en acuerdo con la llamada «teoría de los campos» de Willis (1952) y con los trabajos de Zimmerman (1955), obteniendo tumores de distintas líneas al inducir tumores experimentales por medio de irradiación con perlas de metilcolantreno. Sin embargo, cada vez toma más cuerpo la idea de una génesis formal del tumor a partir de una única o unas pocas células.
Un segundo mecanismo se basa en la posibilidad de que un determinado tumor sea capaz de inducir el crecimiento tumoral de una estirpe celular adyacente, previamente normal (Russell y Rubinstein 1989). Este mecanismo, que en último termino concluye con el desarrollo de dos líneas celulares tumorales distintas, se ha invocado en la génesis de los gliosarcomas e, incluso en sentido inverso, en los sarcogliomas (Lalitha y Rubinstein 1979).
Contrariamente, existen autores que defienden una génesis a partir de una única célula bi o multipotencial, capaz de desarrollarse en ambos sentidos (Slowick y cols 1985). Así, Raff y cols (1983) y Raff y cols (1984) han demostrado que cultivos celulares de células gliales en periodos embrionarios, pueden evolucionar hacia astrocitos o hacia oligodendrocitos, dependiendo del tipo de medio de cultivo que se añada a los explantos así como la existencia de una determinada constelación de expresiones inmunohistoquímicas. En este mismo sentido figuran los trabajos de De La Monte (1989) según los cuales, en el cerebro fetal existirían dos líneas celulares de las que una contiene Ran-2 y no posee antígeno A2B5 que daría lugar exclusivamente a astrocitos tipo I y otra, desprovista de Ran-2 y que posee antígeno A2B5 que podría dar lugar indistintamente a astrocitos tipo II o a oligodendrocitos. Otra posibilidad sería la regresión a un estadio anterior del desarrollo ya que Choi y Kim (1984) han demostrado la expresión temporal de GFAP en oligodendroglía embrionaria de la médula espinal. Esta íntima relación explicaría la transformación de la oligodendroglía en astrocitos en los casos de leucodistrofia metacromática, explicando así la gliosis de los estadios terminales de este proceso.
Por último, los estudios más modernos de biología molecular han proporcionado resultados contradictorios. De un lado no hay diferencias genéticas entre las áreas oligodendrogliomatosas y astrocitomatosas. Reifenberg y cols (1944) y Kraus y cols (1995) han demostrado pérdida de alelos en 1p y 19q en ambas fracciones de forma que no parece haber diferencias genéticas sustanciales entre las áreas astrocitomatosas y oligodendrogliomatosas.
El estudio de nuestros casos ha confirmado por un lado, la existencia de una población de astrocitos adultos en el interior de los oligodendrogliomas, claramente relacionados con la gliosis peritumoral (Escalona Zapata 1994), y que son claramente independientes de células capaces de expresar GFAP y que forman parte de la población tumoral. Este tipo de células es el que forma nuestros grupos I y II y por lo tanto no forman parte intrínseca del tumor.
Los hechos son bien distintos en los tumores de los grupos III y IV de forma que en nuestro material, se puede establecer la siguiente secuencia morfológica:
A) Células redondas de núcleo central semejantes en todo a los oligodendrocitos clásicos, pero capaces de expresar argentofilia y GFAP en forma de un halo perinuclear desprovisto de expansiones.
B) Células semejantes a las anteriores, unas veces con una única expansión positiva que les da un aspecto en forma de coma y otras, con dos o pocas más.
C) Células de tamaño algo mayor, con varias expansiones desprovistas de conexiones vasculares evidentes. Estos tipos celulares corresponden a las células eosinófilas y a algunos minigemistocitos de las coloraciones con H-E.
D) Células de tamaño algo mayor, pero siempre menores que los astrocitos, frecuentemente con núcleos ovalados y citoplasma somático abundante, argentófilo y con expresión de GFAP, del que emergen varias expansiones divergentes de las que algunas terminan implantándose en la adventicia vascular.
Que la oligodendroglía tumoral es capaz de expresar marcadores astrocíticos bajo ciertas condiciones, queda avalado por los resultados obtenidos por nosotros por medio del cultivo de tejidos. Con la técnica a corto plazo, se ha obtenido expresión de GFAP en todos los casos cultivados. Los 11 cultivos fueron controlados exhaustivamente con histología, no sólo del tumor original sino de los fragmentos explantados, para evitar errores de muestreo, y descartar que las áreas estudiadas procedieran de la gliosis peritumoral. De especial significación fue uno de los casos que mostró un patrón eosinófilo y que creció con arreglo al patrón oligodendróglico clásico, sin perder la morfología original panzuda y la colorabilidad eosinófila.
Del mismo modo, 7 de las 8 líneas estables obtenidas a partir de otros tantos oligodendrogliomas, exhibieron la habitual imagen de células pequeñas, de núcleo redondo y citoplasma escaso con expansiones cortas y también escasas, que apenas se modificó durante los sucesivos pases. Todos estos casos expresaron GFAP al cabo del tiempo.
De este modo, en base a nuestros estudios con impregnaciones argénticas, inmunohistoquímica y cultivos celulares, parece poder descartarse la posibilidad de un crecimiento tumoral inicialmente doble y, dada la íntima relación entre los astrocitos tipo 2 de De la Monte y la oligodendroglía, lo más probable que nos hallemos ante un fenómeno de metaplasia astrocítica en seno de la proliferación oligodendrogliomatosa inicial. Bien es cierto que la metaplasia no ha sido invocada apenas en la patología del sistema nervioso salvo el caso ya comentado de la leucodistrofia metacromática (Greenfield 1976), explicada por metaplasia de una oligodendroglía cada vez más escasa. Pero desde el punto de vista de la patología general, estirpes celulares más o menos emparentadas pueden dar lugar a este fenómeno tal y como sucede en los adenocarcinomas endometriales y vesiculares con áreas epidermoides, los carcinomas epidermoides broncopulmonares desarrollados sobre un epitelio inicialmente cilíndrico, los raros carcinomas epidermoides mamarios y el clásico ejemplo del adenoma pleomorfo de las glándulas salivales.
En consecuencia, creemos que pueden alcanzarse las siguientes conclusiones:
A. Aun cuando buena parte del componente astrocitario de los oligodendrogliomas este formado por células atrapadas dependientes de la gliosis peritumoral, los tumores mixtos oligodendroastrocitomatosos son una realidad indudable.
B. Las teorías que se basan en el crecimiento simultáneo de dos estirpes celulares distintas o en la inducción de una población tumoral sobre otra contigua, parecen carecer de bases teóricas suficientes.
C. Dadas las íntimas relaciones entre oligodendrocitos y astrocitos durante el desarrollo embrionario, parece más probable un origen a partir de una línea única común a ambos.
D. Consecuentemente, creemos que los oligodendroastrocitomas deben considerarse como oligodendrogliomas con metaplasia astrocítica difusa o focal.
BIBLIOGRAFÍA
Cooper, ERA. The relation of oligocytes and astrocytes in cerebral tumors. J Pathol 1935; 41: 259-266.
De Buscher J, Scherer. Les gliomes de l’encephale L’edition Universelle. Bruxelles 1942.
Hart MN, Petito CK, Earle KM. Mixed gliomas. Cancer 1974; 33: 134-140.
Escalona-Zapata J. Uncommon oligodendrogliomas. Acta, Neuropathol. 1981, suppl 7, 94.
Meneses ACO, Kepes JJ, Sernberg NH. Astrocytic differentiation of neoplastic oligodendrocytes. J Neuropath Exp Neurol 1982; 41: 368.
Harpers MJHM, Budka H. Glial Fibrillay Acidic Protein in oligodendroglial tumors: Gliofibrillary oligodendroglioma and transitional oligoastrocytoma as subtypes of oligodendroglioma. Acta Neuropathol 1984; 64: 265-272.
Escalona-Zapata J. Astrocytes in brain tumors. Differentiation or trapping? Histol Histopathol 1994; 9: 325-
Río-Hortega, P. Del. El metodo del carbonato de plata. Revisión general de sus técnicas y aplicaciones en histología normal y patológica. Arch Histol Normal y Patol (B. Aires) 1942; 1: 165-206 y 329-362; 1943; 2: 231-246 y ,577-604.
Polak M. Blastomas del sistema nervioso central y periferico. Lopez Libreros Ed. B. Aires 1966.
Kersting G. Die Gewebszüchtung menschlicher Hirngeschwülste. Springer. Berlin 1961.
Escalona-Zapata J, Díez Nau MD. Estudio de los aastrocitomas y sus derivados por medio del cultivo de tejidos. Patología (Madrid) 1983; 16: 23-45.
Miranda Nieves G. Caracteristicas del crecimiento in vitro de las neoplasias gliales. Tesis doctoral Universidad de Sevilla 1989.
Cases Huerta MJ. Estudio del oligodendroglioma y sus variantes por medio del cultivo de tejidos a corto plazo. Tesina de Licenciatura. Universidad Complutense. Madrid 1989.
Escalona-Zapata J. Tumores del sistema nervioso central. Ed Complutense. Madrid 1996.
Rio-Hortega P, Del. Tercera aportacion al conocimiento morfologico e interpretacion funcional de la oligodendroglia. Mem. R Soc Esp Hist Nat 1928; 14: 5-122.
Burger PC, Scheithauer BW. Tumors of the central nervous system. A.F.I.P. 3a serie. Washington D.C. 1994.
Willis RA. The spread of the tumours in the human body. Butterworth Co, Ltd. London 1952.
Zimmerman HM. The nature of gliomas as revealed by animal experimentation. Am J Pathol 1955; 31: 1-30.
Lalitha VS, Rubinstein LJ. Reactive glioma in intracranial sarcoma: a form of mixed sarcoma and glioma (sarcoglioma). Report of eigth cases. Cancer 1979; 43: 246-257.
Slowik F, Jellinger K, Gaszo L, Fisher J. Gliosarcomas: histological, immunohistochemical, ultrastructural and tissue culture studies. Acta Neuropathol 1985; 67: 201-210.
Raff MC, Abney ER, Miller RH. Two gilal lineages diverge prenatally in rat optic nerve. Dev Biol 1984; 106: 53-60.
Raff MC, Abney ER, Fok-Seang J. Reconstitution of a developmental clock in vitro. A critical role for astrocytes in the timing of oligodendrocyte differentiation. Cell 1985; 42: 61-69.
De la Monte SM. Uniform lineage of oligodendrogliomas. Am J Pathol 1989; 135: 529-540.
Lubetzki Zalk.
Choi BH, Kim RC. Expression of glial fibrillary acidic protein in immature oligodendroglia. Science 1984; 223: 407-408.
Greenfield JG. Neuropathology 3a edicion. E. Arnold Ltd.: London 1976.
Reifenberger J, Reifenberger G, Liu I, James CD, Wechsler W, Collins VP. Molecular genetics analysis of oligodendroglial tumors shows preferential alelic delections on 19q and 1p. Am J Pathol 1994; 145: 1175-1190.
Kraus JA, Koopmann J, Kaskel P, Mainz D, Brandner S, Schramm J, Louis DN, Wiestler OD, von Deimling A. Shared allelic losses on chromosomes 1p and 15q suggest a common origin of oligodendroglioma and oligoastrocytoma. J Neuropathol Exp Neurol 1995; 54: 91-95.